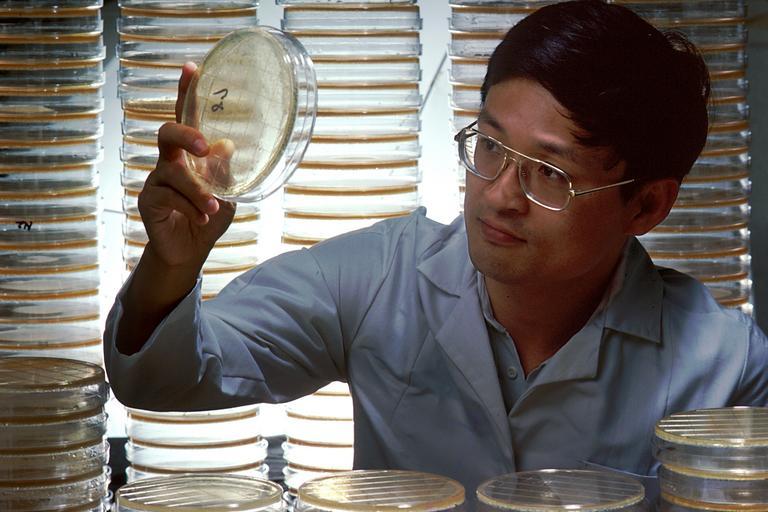

MAKE A MEME
View Large Image
| View Original: | Agar plates (1).jpg (2700x1800) | |||
| Download: | Original | Medium | Small | Thumb |
| Courtesy of: | commons.wikimedia.org | More Like This | ||
| Keywords: Agar plates (1).jpg A bacteria mix is spread on an agar plate A male Asian scientist holding an agar plate From that plate a recombinant clone containing a gene of interest is lifted Then large amounts of the bacteria are grown and the plasma is harvested The DNA is then extracted and used for studying genes including oncogenes Topics/Categories People -- Adult People -- Health Professional Science and Technology -- Laboratory Techniques/Equipment Type Color Photo Source Dr Stuart Aaronson Laboratory Of Cellular And Molecular Biology Bill Branson Photographer 2226 1985-09 Reuse Restrictions None - This image is in the public domain and can be freely reused Please credit the source and/or author listed above Bill Branson Photographer PD-USGov-HHS-NIH Media from National Cancer Institute Visuals Online Images uploaded by Fæ Petri dishes cultures Microbiologists People with lab coats | ||||